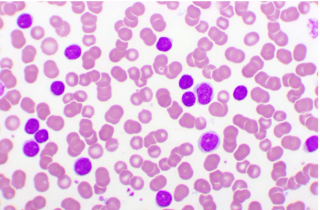
Image Credit: © jarun011 - stock.adobe.com

Chronic Lymphocytic Leukemia
Latest News

Latest Videos

CME Content
More News

Umoja Biopharma's UB-VV111 gains FDA fast track designation, revolutionizing CAR T-cell therapy for relapsed lymphoma and leukemia patients.

September highlights Blood Cancer Awareness Month, focusing on education, early diagnosis, and support for multiple myeloma, lymphoma, and leukemia patients.

Ibrutinib combined with venetoclax significantly improved measurable residual disease and progression-free survival in patients with chronic lymphocytic leukemia.

New research reveals that immunoglobulin replacement therapy fails to lower infection-related hospitalizations in those with chronic lymphocytic leukemia (CLL), raising treatment concerns.

Acalabrutinib shows improved safety and survival rates in chronic lymphocytic leukemia (CLL), reducing risks of mortality and cardiovascular complications.

Birelentinib gains FDA fast track designation, offering hope for relapsed CLL/SLL patients resistant to current BTK and BCL2 therapies.

Pirtobrutinib shows promising results in a head-to-head trial against ibrutinib for chronic lymphocytic leukemia (CLL)/small lymphocytic leukemia (SLL).

Targeting BRD4 with BET inhibitors shows promise in reversing immune suppression by myeloid-derived suppressor cells in chronic lymphocytic leukemia.

An adjusted analysis of the ALPINE and ASCEND trials revealed a statistically significant progression-free survival advantage for zanubrutinib.

New research highlights the lower infection risk with zanubrutinib compared with venetoclax in CLL/SLL treatment, offering safer options for patients.

Obecabtagene autoleucel shows promising efficacy and safety in treating relapsed/refractory B-ALL, benefiting patients of all ages, including older adults.

The data from the 5-year analysis of arm C validate and support the efficacy and safety of zanubrutinib for treatment-naive patients with CLL/SLL harboring del(17p).

The approval of the tablet formulation of zanubrutinib covers all 5 approved indications of the Bruton tyrosine kinase inhibitor.

Ibrutinib plus venetoclax shows promising long-term survival rates, including those who are considered high risk.

The data from the phase 3 SEQUOIA study are to be presented at the 2025 ASCO Annual Meeting.


Ibrutinib offers comparable survival outcomes for high-risk chronic lymphocytic leukemia patients, challenging traditional prognostic markers in real-world settings.

There was no significant increase in severe adverse events associated with statin use.

Explore the latest advancements in chronic lymphocytic leukemia treatment, focusing on BTK and BCL2 inhibitors, monoclonal antibodies, and patient management strategies.


Undetectable minimal residual disease rates improved with ongoing therapy.

Siremadlin is a novel, investigational, second-generation antagonist that binds to MDM2.

Pharmacists performed weekly toxicity and tumor lysis syndrome monitoring.

Patients with chronic lymphocytic leukemia (CLL) show weakened T-cell memory responses to COVID-19 vaccination.

Reducing the dose of ibrutinib following adverse events improved tolerability without compromising clinical efficacy in chronic lymphocytic leukemia (CLL).